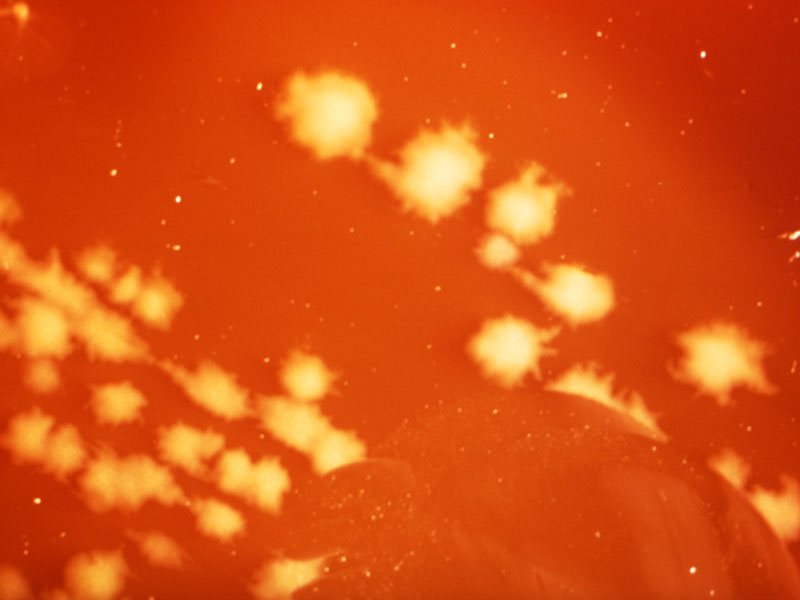

Bioasekuracja w gospodarstwie rolnym – jak skutecznie zabezpieczyć produkcję przed ASF i ptasią grypą?
02-04-2026

Ptasia grypa (AI), choroba Newcastle (ND) i ukryta rola śluzu Dlaczego czysta woda i prawidłowa biologia organizmu ptaka mają dziś kluczowe znaczenie?
20-02-2026

Strategie nawożenia trwałych użytków zielonych w kształtowaniu jakości paszy objętościowej
13-02-2026

Juz za tydzień największe specjalistyczne targi dla fachowców produkcji zwierzęcej w Polsce
11-02-2026

Euromilk uruchamia limitowany program: „Weź EM LIZARD na próbę” i przetestuj robota w swojej oborze przez 30 dni
09-02-2026

Rolniczy handel detaliczny a sprzedaż bezpośrednia – możliwości sprzedaży produktów z ferm drobiu
06-02-2026

Znaczenie identyfikacji płci zarodków kurzych i piskląt jednodniowych w produkcji drobiarskiej
05-02-2026

Uniwersytet Columbia przetestuje nową strategię zwalczania ptasiej grypy na fermach drobiu
04-02-2026

Dlaczego indyki bywają agresywne? Poznaj ich naturę i dowiedz się, jak ograniczyć konflikty w stadzie
08-01-2026

Kiszonki, które budują wydajność: jak przygotować paszę, by nie tracić plonów i pieniędzy?
20-11-2025

Przetworzone białko drobiowe w żywieniu świń - nowoczesna, opłacalna i bezpieczna alternatywa dla soi
18-11-2025

Od odporności do zysku – jak naturalne substancje aktywne wspierają zdrowie stada i spokój hodowcy
18-11-2025

Kiełki fasoli – naturalny sposób na zdrowsze prosięta i tańszą produkcję? Oto, co mówią badania
17-11-2025

Substancje przeciwbakteryjne w paszach dla drobiu – przyczyny i konsekwencje ich występowania
27-10-2025

Najczęstsze problemy zdrowotne kur w chowie przydomowym: Schorzenia spowodowane nieprawidłowym żywieniem
20-10-2025

Euromilk z tytułem Innowacji Roku za robota EM Lizard podczas gali „Złota Setka Polskiego Rolnictwa”
13-10-2025

Powstaje nowoczesna wytwórnia premiksów - Vilomix i Blattin Polska inwestują w nową fabrykę
09-10-2025

Mieszanka paszowa na bazie sorgo – uprawa, wartość odżywcza, zastosowanie w żywieniu bydła mięsnego
07-10-2025

Skuteczność dodatków wiążących mikotoksyny i potencjalne ryzyko interakcji ze składnikami odżywczymi
29-09-2025

Praktyczne skutki ograniczenia ilości białka surowego w paszy dla brojlerów w kontekście wydajności, zdrowia i zrównoważonego rozwoju
22-09-2025

Prototheca – ukryty wróg w stadzie mlecznym. Co musisz wiedzieć o nietypowym zapaleniu wymienia?
15-09-2025

Nowy sklep RolnikKupuje.pl – miejsce, gdzie rolnik znajdzie wszystko do maszyn John Deere!
14-08-2025

Mechanizmy wpływu stresu cieplnego na integralność jelita, stan zapalny i mikroflorę u kurcząt
08-08-2025

Stres cieplny u drobiu – jak zmienić skład paszy, aby poprawić zdrowie i wydajność ptaków latem?
04-07-2025

Określenie optymalnego stosunku standaryzowanej strawności jelitowej (sid) argininy do lizyny u prosiąt w okresie odchowu o masie ciała od 6 do 13 kg
25-06-2025

Hala wielosezonowa w gospodarstwie – czy jedna przestrzeń wystarczy na zbiory, sprzęt i pasze?
25-04-2025

Polskie drobiarstwo uniknęło drastycznych obostrzeń – Komisja Europejska przyjęła kompromisowy „Plan działania”
16-04-2025

🔔 Obowiązkowe szczepienia kur i indyków – nowe przepisy w związku z rzekomym pomorem drobiu
11-04-2025

System udojowy jest jak organizm człowieka – odkryj klucz do zdrowia stada i jakości mleka
06-02-2025

AGRO-PREMIERY kierunek rolnictwo 5.0 – sukces nowoczesnego rolnictwa na Międzynarodowych Targach Poznańskich
05-02-2025

Jesteśmy wyjątkowymi ekspertami w mięsie indyczym – mięsie wysokiej klasy, zdrowszym niż inne
17-01-2025

Obniżenie poziomu białka ogólnego korzystnie wpływa na wzrost, dobrostan i zdrowie jelit kurcząt brojlerów
12-12-2024

Zmniejszenie zawartości białka ogólnego w diecie kur niosek może mieć pozytywny wpływ na utrzymanie wydajności, masę i jakość jaj
12-11-2024

Zmniejszenie ognisk grypy ptaków w Europie: potencjalne ryzyko i nowe strategie walki z HPAI
23-09-2024

Innowacyjna metoda kontroli produkcji paszy – obniżająca śmiertelność macior i poprawiająca wyniki produkcyjne
16-09-2024

Optymalizacja odchowu prosiąt: rola wczesnego żywienia i funkcjonalnych białek plazmy w braku stosowania farmaceutycznych poziomów ZnO
16-09-2024

Badania porejestrowe odmian kukurydzy – najlepsze odmiany pod względem poszczególnych cech
01-06-2023

Targi Ferma – największe specjalistyczne targi dla fachowców produkcji zwierzęcej w Polsce
30-11-2022

Jaki powinien być stosunek waliny do lizyny w paszy do uzyskania optymalnych parametrów użytkowych u odsadzonych prosiąt?
20-10-2022

Izoleucyna, brakujące ogniwo w kluczowej roli aminokwasów w bezpiecznym odsadzeniu prosiąt
31-08-2022
35% naszego importu mięsa indyczego to skrzydła. Sprawdź jaki był handel indykami w 2021 r.
31-03-2022

Uboje drobiu rzeźnego w UE w I półroczu 2021 r. - sprawdź ile straciła Polska przez ptasią grypę
06-09-2021

Uboje drobiu rzeźnego w UE w I półroczu 2021 r. - sprawdź ile straciła Polska przez ptasią grypę
06-09-2021

MRiRW będzie wnioskować do KE o pomoc dla drobiarzy – deklaracje należy składać do 10 października
01-09-2021

Białko zwierzęce w paszach - TAK, ale z pełnowartościowych produktów nadających się do spożycia przez ludzi
24-08-2021

Od dziś można składać wnioski na wsparcie dla grup producentów - sprawdź ile możesz otrzymać!
15-04-2021

Tylko u nas! Szczegółowy raport o występowaniu ognisk ptasiej grypy w sezonie jesienno-wiosennym 2020-2021
13-04-2021
Popularne wiadomości